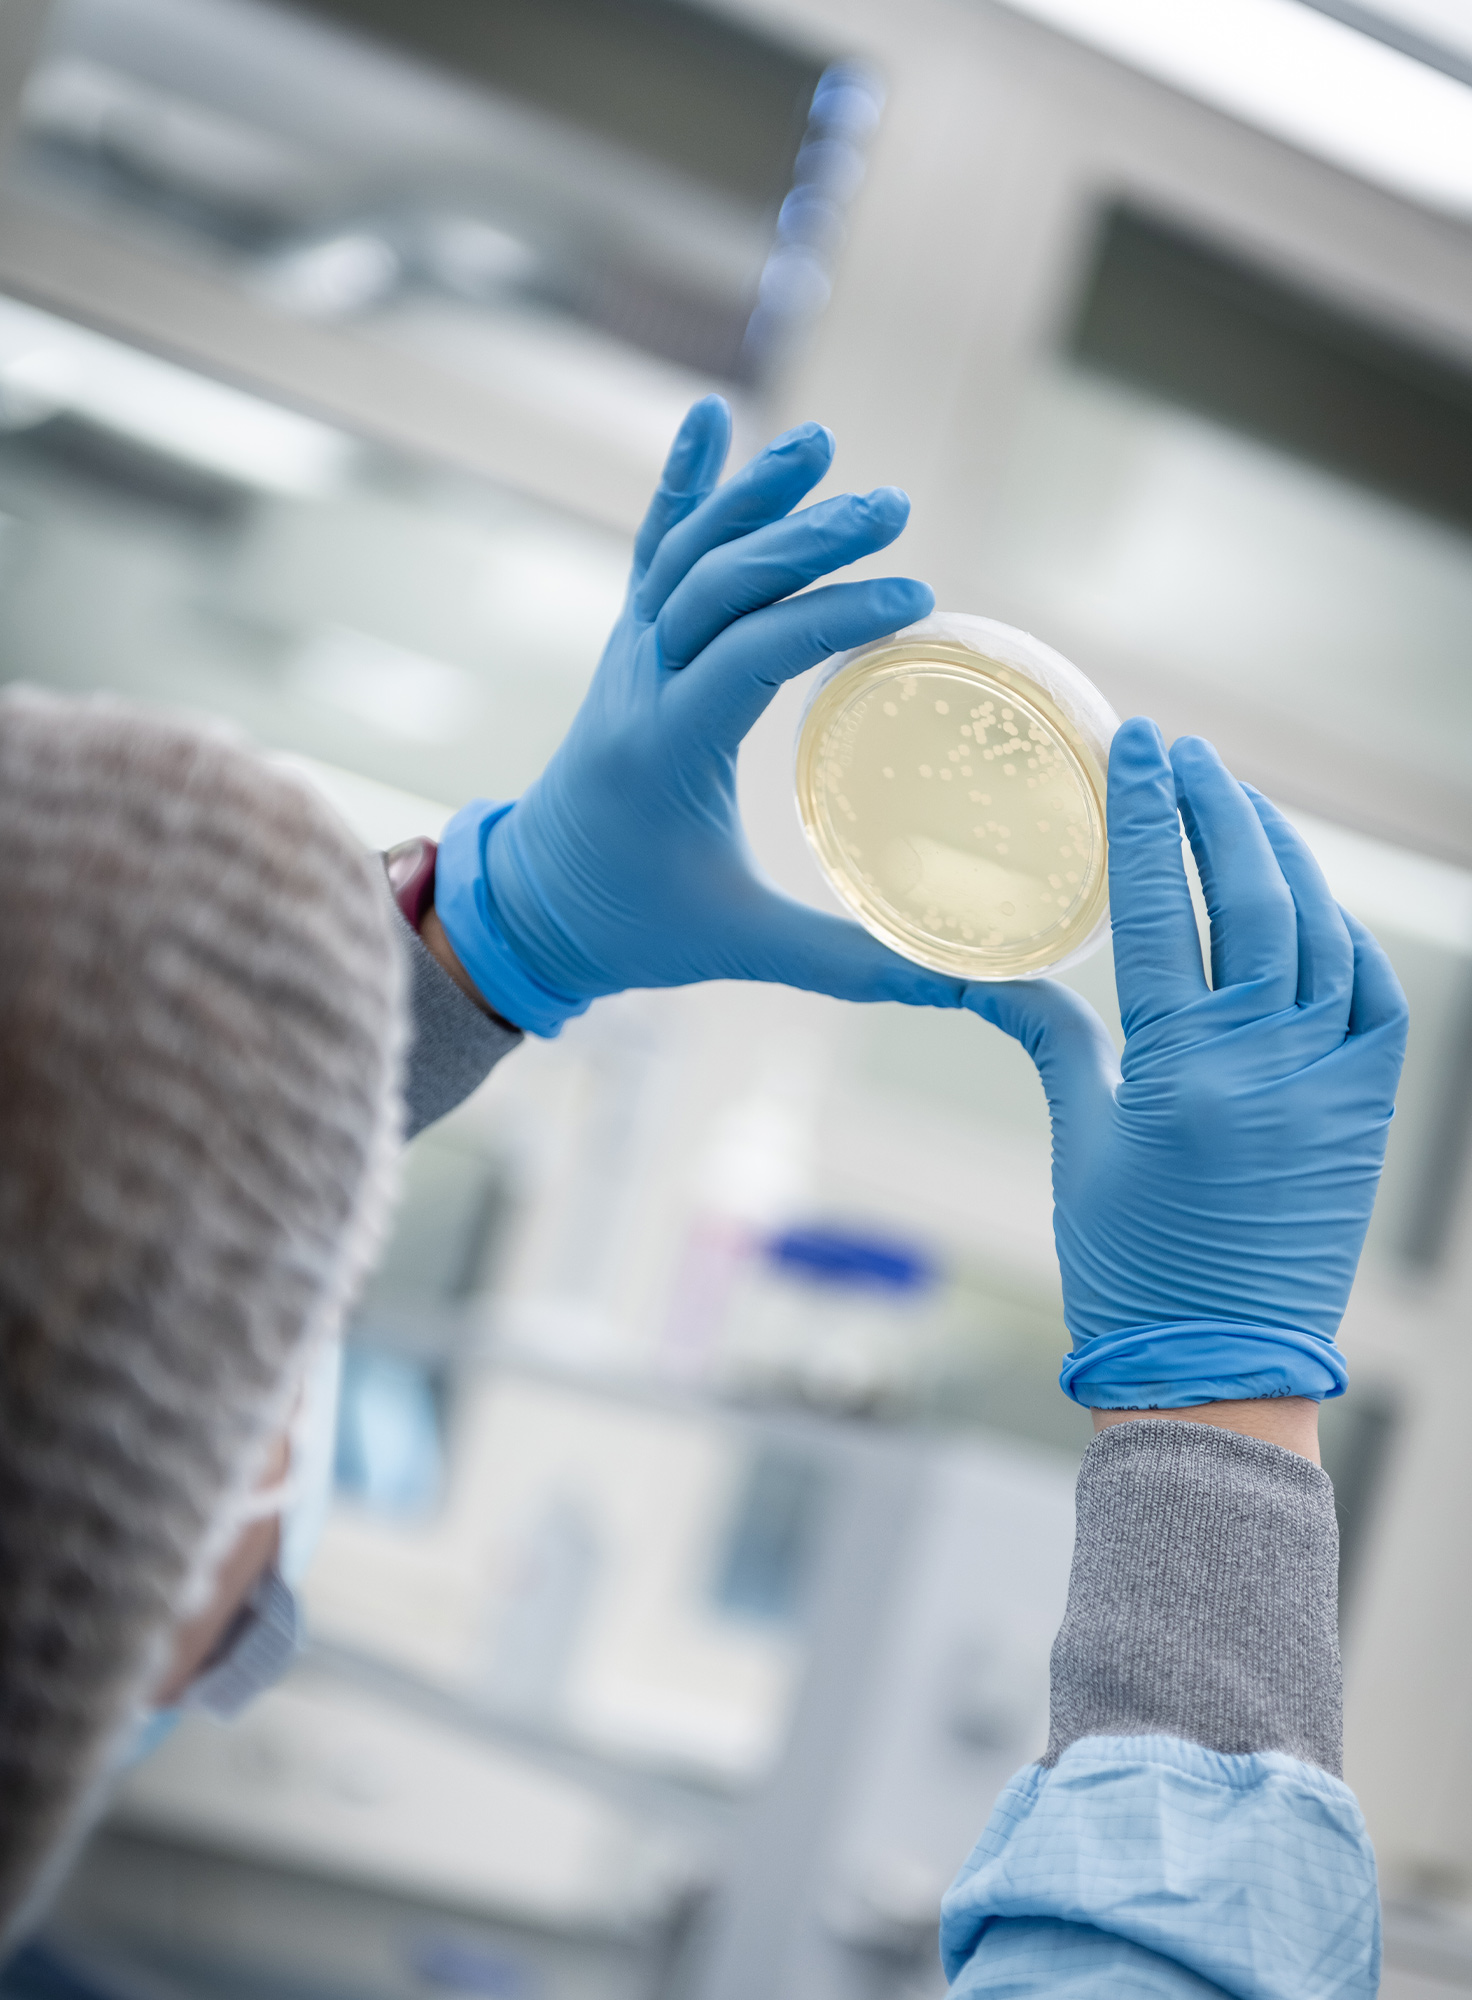

Which of the Following Best Describes Serial Dilution
Serial dilutions involve diluting a stock or standard solution multiple times in a row. Move Volume Final Volume DF -1.
1 8 Serial Dilutions And Standard Curve Biology Libretexts
A thick layer of hydrogen gas B.
. 1 M 01 M 001 M 0001 M and. The diagram shows a serial dilution. Mostly water surface with some areas of land.
Choose all that apply. It could be proper or common noun. For example a ten-fold serial dilution could result in the following concentrations.
In simple words serial dilution is the process of stepwise dilution of a solution with an associated dilution factor. A Serial dilution is a series of dilutions with the dilution factor staying the same for each step. A unit of spoken language that usually contains only one vowel sound is called a Weegy.
Which best describes what a central bank uses monetary policy to do. Starting with a stock solution of glucose with a molarity of 0750 M four solutions are prepared by serial diluton. The source of dilution material for each step comes from the diluted material of the previous.
Sometimes a group of cells forms a single colony. Cloudy and hot with lots of Volcano C. Up to 25 cash back Which of the following uses serial dilutions of a serum sample to detect levels of circulating antibodies in the srum - Answered by a verified Tutor We use cookies to give you the best possible experience on our website.
Which of the following best describes the surface of the Planet Earth. The dilution factor or the dilution is the initial volume divided by the final volume. Which of the following are common tools of the microbiology laboratory.
DF V i V f. The following sentence containing a collective noun is letter B. Why do we use the term colony-forming units instead of cells when expressing concentration of bacteria in.
Digital Biology Lesson Cells Chemical Energy Distance Learning Chemical Energy Digital Learning Activities Biology Lessons. Central banks generally agree that intervention is necessary to stimulate the economy or maintain a desired foreign exchange rate. Price stability is the best contribution that monetary policy can make to economic growth.
Which of the following best describes serial dilution. 14 Serial Dilution. Complementary Genes Interaction Sweet Pea Cross Gene Interactive Latest Discoveries.
The first dilution is 1 10 the second dilution is 1 5 the third dilution is 1 4. Serial Dilution A serial dilution is simply a series of simple dilutions which amplifies the dilution factor quickly beginning with a small initial quantity of material ie bacterial culture a chemical orange juice etc. Typically the dilution factor remains constant for each dilution resulting in an exponential decrease in concentration.
Serial dilution as the name suggests is a series of sequential dilutions that are performed to convert a dense solution into a more usable concentration. What is the total dilution factor of this three step serial dilution procedure. You then repeat this procedure two more times.
The dilution factor is the inverse of the concentration factor. The easiest method is to make a. Identical volumes of a bacterial sample are transferred to several Petri dishes.
A serial dilution is any dilution in which the concentration decreases by the same factor in each successive step. For example if you take 1 part of a sample and add 9 parts of water solvent then you have made a 110 dilution. Melted agar is poured into a series of sterile Petri plates.
DF V_iV_f For example if you add a 1 mL sample to 9 mL of diluent to get 10 mL of solution. O microaerophiles T-streaks using the inoculation loop dilute bacterial cultures through dilution by distance serial dilution selective media Which of the following terms best describes a technique designed to prevent contamination. In serial dilutions you multiply the dilution factors for each step.
54 Which of the following describes the events of apoptosis. A p 02 q 002 r 0002 s 00002 B p 1 q 05 r 02 s 01 C p 1 q 05 r 025 s 0125 D p 02 q 01 r 005 s 0025 Your answer 1 OCR 2018. A A solution containing 21 104 at a 10-1 dilution b A solution containing 19 104 at a 10-2 dilution c A solution containing 16 107 at a 10-6 dilution d A solution containing 25 107 at a 10-2 dilution.
Each tube in a set of tubes is a dilution of the previous tube. A serial dilution is a series of sequential dilutions used to reduce a dense culture of cells to a more usable concentration. A serial dilution is a series of sequential dilutions used to reduce a dense culture of cells to a more usable concentration.
Apoptosis is a biological process which occurs in all multicellular organisms including plants and animals. A dilution series is a succession of step dilutions each with the same dilution factor where the diluted material of the previous step is used to make the subsequent dilution. A collective noun is a group of items taken as one item with the words around the main noun clarifying the noun.
To make a dilution series use the following formulas. Which of the following is true regarding the carbon cycle and food webs. Which of the Following Provides an Example of Epistasis.
Group of answer choices. The Final Dilution Factor In a three step serial dilution. Serial Dilution Definition.
M1V1 M2V2 M1 stock solution molarity V1 stock Solution volume M2 dilute solution molarity V2 dilute solution volume ---- Here View the full answer Transcribed image text. Which of the following would produce a countable plate. The concentration factor is the initial volume divided by the final solution volume.
Which of the options A to D shows the correct concentrations of sucrose in tubes p s. In serial dilutions you multiply the dilution factors for each step. Which of the following best describes serial dilution.
This is how standard curves for ELISA can be made. Cold rocky and covered with red dust D. The legislature met in secret session B.
Why does plate count have an advantage. Serial dilutions involve diluting a stock or standard solution multiple times in a row. Which best describes a central banks primary role.
It only identifies viable cells.
Antimicrobial Activity Of A Novel Spanish Propolis Against Planktonic And Sessile Oral Streptococcus Spp Scientific Reports
Burkholderia Pseudomallei Pathogenesis In Human Skin Fibroblasts A Bsa Type Iii Secretion System Is Involved In The Invasion Multinucleated Giant Cell Formation And Cellular Damage
Pin By Vera On Python Python Usb Adapter Data Logger
Persistence Of Plasmids Targeted By Crispr Interference In Bacterial Populations Pnas
Protocol For Using Artificial Lipid Droplets To Study The Binding Affinity Of Lipid Droplet Associated Proteins Sciencedirect
Steps To Clean And Sanitize A Food Processing Nsf International
Impact Of The Metabolic Activity Of Streptococcus Thermophilus On The Colon Epithelium Of Gnotobiotic Rats Journal Of Biological Chemistry
Quantification Of Nadh Ubiquinone Oxidoreductase Complex I Content In Biological Samples Journal Of Biological Chemistry
Mantis Microfluidic Liquid Handler Formulatrix
Workflow Centred Open Source Fully Automated Lung Volumetry In Chest Ct Clinical Radiology
Protocol For Serial Organoid Formation Assay Using Primary Colorectal Cancer Tissues To Evaluate Cancer Stem Cell Activity Sciencedirect
Pin By Vera On Python Python Usb Adapter Data Logger
Machine Learning Approach For Predicting Single Cell Lag Time Of Salmonella Enteritidis After Heat And Chlorine Treatment Sciencedirect
Diagnostico Pruebas Bioquimicas Bioquimica Microbiologia Biologia

Comments
Post a Comment